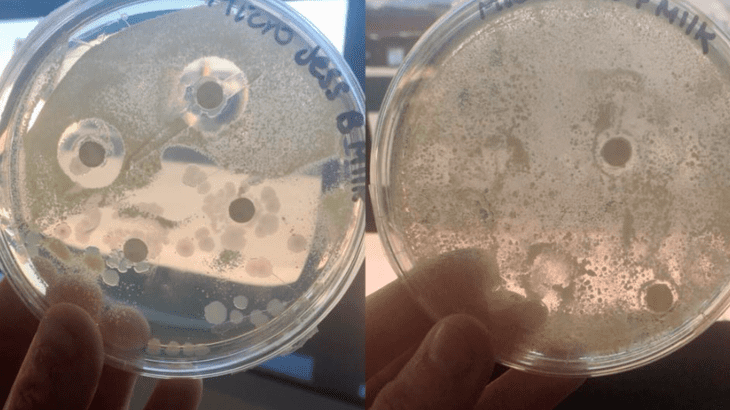

If the posting of this site is beneficial to our suport by spreading article posts of this site to social media marketing accounts which you have such as for example Facebook, Instagram and others or can also bookmark this blog page.

Un Esperimento Su Latte Materno E Latte Artificiale Il Risultato E Incredibile Gacha Game Genshin Impact

Amazon It Il Tamburo Di Latta Grass Gunter Bianchi B Libri Gacha Game Genshin Impact

Tavolo Del Latte Dal Viminale A Cagliari Prefettura Si Arrivera A Un Accordo Cagliari Vistanet Gacha Game Genshin Impact

Latte E Prodotti Lattiero Caseari Portale Informativo Sulla Produzione Di Alimenti E Dolciumi Gacha Game Genshin Impact

C Era Una Volta Il Latte A Domicilio Nella Citta Delle 120 Mercerie Gazzetta Di Mantova Mantova Gacha Game Genshin Impact

Acquista Vendite Calde Bambini Strumenti Musicali Giocattolo Bambini Drum Kit Set Tamburo Di Plastica Colorato A 11 15 Dal Top777 Dhgate Com Gacha Game Genshin Impact

Il Tamburo Di Drake Illustrazione Da Rake S Tamburo E Altre Canzoni Del Mare 1905 Foto Stock Alamy Gacha Game Genshin Impact

Lattalatte Instagram Posts Gramho Com Gacha Game Genshin Impact

Africaland Storie E Culture Africane Tamburi Del Burundi Theroyaldrummersofburundi Una Magica Storia Gacha Game Genshin Impact

Gunther Grass E Il Tamburo Di Latta La Poesia E Lo Spirito Gacha Game Genshin Impact
More From Gacha Game Genshin Impact